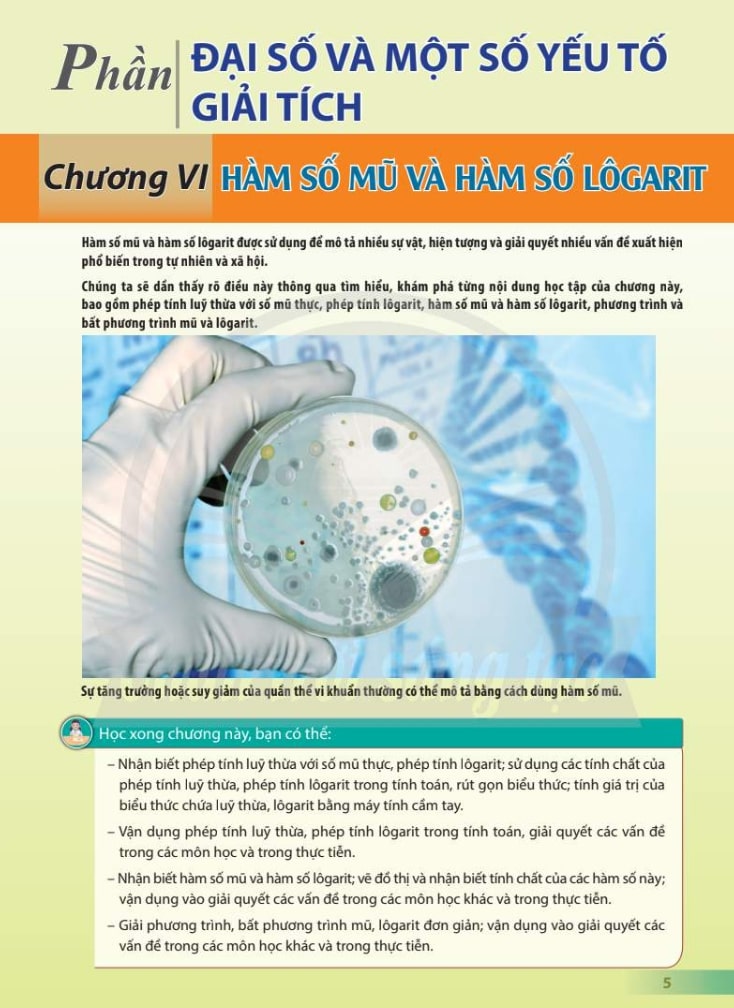

Toán 11 Tập 2 Chân Trời Sáng Tạo PDF – Rèn Tư Duy Logic Và Kỹ Năng Giải Bài Tập Hiệu Quả

Toán 11 Tập 2 Chân Trời Sáng Tạo là cuốn sách giáo khoa giúp học sinh lớp 11 tiếp cận kiến thức toán học hiện đại thông qua phương pháp học tập tư duy, khám phá và vận dụng thực tế. Sách được biên soạn công phu, bám sát chương trình của Bộ Giáo dục và Đào tạo, với nội dung bao gồm các chuyên đề quan trọng như giới hạn, đạo hàm, lượng giác và xác suất.
Mỗi bài học trong SGK Toán 11 Tập 2 Chân Trời Sáng Tạo được trình bày rõ ràng, kết hợp hình ảnh minh họa sinh động và bài tập đa dạng, giúp học sinh rèn luyện khả năng tư duy logic, giải quyết vấn đề và ứng dụng toán học vào đời sống. Đây là tài liệu học tập hữu ích không chỉ cho học sinh mà còn cho giáo viên và phụ huynh trong quá trình đồng hành cùng con em học tập hiệu quả.
Tải Sách Toán 11 Tập 2 Chân Trời Sáng Tạo PDF Miễn Phí
Vai trò của Bài 1 trên trang 32
Khi mở Toán 11 Tập 2 Chân Trời Sáng Tạo trang 32, học sinh sẽ bắt gặp Bài 1, phần bài tập cơ bản nhưng mang tính nền tảng cao. Đây là bước mở đầu quan trọng, giúp học sinh nắm chắc các kỹ năng cần thiết trước khi đi sâu vào các dạng toán phức tạp hơn trong chương trình. Việc hiểu rõ và giải đúng Toán 11 Tập 2 Chân Trời Sáng Tạo bài 1 sẽ tạo tiền đề để học sinh giải quyết hiệu quả các bài tập tiếp theo, đồng thời phát triển tư duy logic, kỹ năng phân tích và khả năng vận dụng kiến thức linh hoạt.
Thông thường, Bài 1 trang 32 liên quan đến phương trình mũ và lôgarit, hai dạng toán quan trọng trong chương trình Toán 11 tập 2. Học sinh cần nhận diện cơ số, biết cách chuyển đổi về cùng cơ số và áp dụng các công thức biến đổi phù hợp. Việc này không chỉ giúp tránh nhầm lẫn khi giải bài mà còn giúp các bạn học sinh rèn luyện khả năng tư duy toán học, suy luận logic theo từng bước.
Hướng dẫn tiếp cận Bài 1 hiệu quả

1. Đọc và hiểu kỹ đề bài
Bước đầu tiên khi học trên Toán 11 Tập 2 Chân Trời Sáng Tạo trang 32 là đọc kỹ từng yêu cầu. Xác định loại phương trình, biến số xuất hiện và các điều kiện đi kèm. Việc này giúp học sinh lập kế hoạch giải quyết bài tập một cách logic, tránh bỏ sót những chi tiết quan trọng. Với Toán 11 Tập 2 Chân Trời Sáng Tạo bài 1, học sinh sẽ thấy các bài tập được thiết kế từ dễ đến khó, giúp từng bước nâng cao kỹ năng.
2. Chuyển đổi cơ số hợp lý
Với các phương trình mũ, việc nhận diện cơ số là bước quan trọng. Ví dụ: bài tập 5^{2x–1}=25 sẽ yêu cầu chuyển đổi 25 thành 5^2 để dễ dàng so sánh mũ. Khi học sinh làm quen với các bước này, tư duy biến đổi biểu thức được rèn luyện một cách chính xác và nhanh chóng. Việc luyện tập thường xuyên giúp các bạn học sinh tự tin hơn khi gặp các bài toán mũ phức tạp trong các chương tiếp theo.
3. Giải phương trình tuyến tính sau khi đặt mũ bằng nhau
Sau khi đưa hai vế của phương trình về cùng cơ số, bước tiếp theo là giải phương trình tuyến tính để tìm x. Đây là giai đoạn củng cố kỹ năng tính toán chính xác và khả năng kiểm tra kết quả. Việc thay nghiệm trở lại đề bài ban đầu để kiểm chứng sẽ giúp học sinh phát hiện lỗi nhanh chóng, đồng thời củng cố kiến thức lý thuyết liên quan.
4. Kiểm tra điều kiện nghiệm
Với các bài lôgarit, học sinh cần đảm bảo biểu thức trong log luôn dương. Đây là bước quan trọng để tránh sai sót và đảm bảo kết quả chính xác. Việc chú ý đến điều kiện xác định cũng giúp học sinh củng cố kiến thức lý thuyết, đồng thời hình thành thói quen kiểm tra bài một cách cẩn thận, khoa học.
5. Ôn tập thêm các dạng bài liên quan
Sau khi hoàn thành Bài 1, học sinh nên tiếp tục làm các bài tập nâng cao và vận dụng. Việc ôn tập này giúp củng cố kiến thức, hình thành kỹ năng phân tích và tư duy linh hoạt. Đồng thời, các bạn sẽ sẵn sàng hơn cho các kỳ thi giữa học kỳ và cuối năm, nơi các dạng bài tương tự xuất hiện dưới nhiều hình thức khác nhau.
Lợi ích của việc học online

Ngày nay, việc tìm Sách Toán 11 Tập 2 Chân Trời Sáng Tạo online đã trở nên dễ dàng, phù hợp với nhịp sống hiện đại. Phiên bản online giúp học sinh tra cứu nhanh trang 32, Bài 1, và các bài tập liên quan mọi lúc mọi nơi, mà không cần mang theo sách giấy cồng kềnh.
Các tài liệu trực tuyến thường đi kèm lời giải chi tiết, video hướng dẫn và bài tập bổ sung, giúp học sinh học chủ động, rèn luyện kỹ năng tự học và tự kiểm tra. Việc học online cũng tạo cơ hội thảo luận nhóm, chia sẻ kinh nghiệm, và học theo nhịp riêng phù hợp với từng cá nhân, đồng thời tiết kiệm thời gian di chuyển.
Mẹo tối ưu hóa việc học Toán 11 Tập 2
-
Lập sơ đồ giải quyết vấn đề
Trước khi bắt tay vào giải bài, vẽ sơ đồ các bước hoặc liệt kê trình tự giải giúp học sinh hình dung phương pháp, giảm thiểu nhầm lẫn và tăng hiệu quả học tập. -
Tích hợp lý thuyết và thực hành
Khi học Toán 11 Tập 2 Chân Trời Sáng Tạo bài 1, hãy ghi chú lý thuyết liên quan trực tiếp vào bài tập. Việc này giúp ghi nhớ kiến thức lâu hơn và dễ dàng vận dụng cho các bài tập tiếp theo. -
Thảo luận nhóm
Chia sẻ kinh nghiệm và phương pháp giải bài tập giúp học sinh phát triển kỹ năng tư duy phản biện, đồng thời học hỏi các cách tiếp cận khác nhau từ bạn bè và giáo viên. -
Tận dụng công cụ online
Các website cung cấp bài tập, lời giải, video hướng dẫn giúp việc học sinh động, sinh động và hiệu quả hơn. Điều này đặc biệt hữu ích khi học sinh cần giải thích chi tiết các bước giải hoặc làm bài tập nâng cao.




